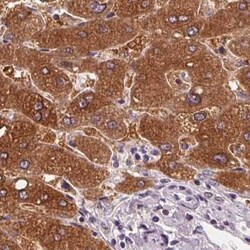
Invitrogen UGP2 Polyclonal Antibody 100 &mu;L | Buy Online | Invitrogen&trade; | Fisher Scientific

missing translation for 'onlineSavingsMsg'
Learn More
Learn More
Invitrogen™ UGP2 Polyclonal Antibody


Descrizione
Immunogen sequence: IFNTNNLWIS LAAVKRLQEQ NAIDMEIIVN AKTLDGGLNV IQLETAVGAA IKSFENSLGI NVPRSRFLPV KTTSDLLLVM SNLYSLNAGS LTMSEKRE Highest antigen sequence indentity to the following orthologs: Rat - 99%, Mouse - 98%.
The enzyme encoded by this gene is an important intermediary in mammalian carbohydrate interconversions. It transfers a glucose moiety from glucose-1-phosphate to MgUTP and forms UDP-glucose and MgPPi. In liver and muscle tissue, UDP-glucose is a direct precursor of glycogen; in lactating mammary gland it is converted to UDP-galactose which is then converted to lactose. The eukaryotic enzyme has no significant sequence similarity to the prokaryotic enzyme. Two transcript variants encoding different isoforms have been found for this gene.

Specifica
Specifica
| Antigene | UGP2 |
| Applicazioni | Immunohistochemistry (Paraffin), Western Blot, Immunocytochemistry |
| Classificazione | Polyclonal |
| Concentrazione | 0.05 mg/mL |
| Coniugato | Unconjugated |
| Formulazione | PBS with 40% glycerol and 0.02% sodium azide; pH 7.2 |
| Gene | UGP2 |
| N. accesso geni | Q16851 |
| Alias gene | pHC379; testis tissue sperm-binding protein Li 58p; UDPG; UDP-glucose diphosphorylase; UDP-glucose pyrophosphorylase; UDP-glucose pyrophosphorylase 1; UDP-glucose pyrophosphorylase 2; UDPGP; UDPGP2; UGP1; Ugp2; UGPase; UGPase 2; UGPP1; UGPP2; uridindiphosphoglucosepyrophosphorylase 2; uridyl diphosphate glucose pyrophosphorylase 2; Uridyl diphosphate glucose pyrophosphorylase-1; UTP-glucose-1-phosphate uridyltransferase; UTP--glucose-1-phosphate uridylyltransferase; UTP--glucose-1-phosphate uridylyltransferase 2 |
| Simboli geni | UGP2 |
| Vedi altri risultati |
Titolo del prodotto
Facendo clic su Invia, l'utente riconosce che potrebbe essere contattato da Fisher Scientific in merito al feedback fornito in questo modulo. Non condivideremo le vostre informazioni per altri scopi. Tutte le informazioni di contatto fornite saranno conservate in conformità con la nostra Politica sulla privacy. Informativa sulla privacy.
Individuate un'opportunità di miglioramento?